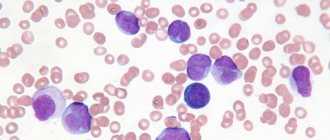

Что такое гидроцефалия?
Термин гидроцефалия образован из двух греческих слов: «гидро» — вода и «цефал» — голова («водянка мозга»). При гидроцефалии происходит значительное скопление спинномозговой жидкости (ликвора) внутри полостей головного мозга, называемых желудочками. Увеличение объема спинномозговой жидкости (СМЖ) возникает при нарушении баланса между вырабатыванием ликвора и его поглощением и дальнейшим выведением из организма. Это может быть результатом недостатка системы кровообращения или чрезмерной продукции ликвора. Гидроцефалия может быть врожденной либо приобретенной. Понятие врожденная гидроцефалия означает, что она появляется с момента рождения. Болезнь может провоцироваться различными факторами: черепно-мозговой травмой, опухолью мозга, некрозом, менингитом и др. Частота этого заболевания высока во всем мире. По данным литературы, гидроцефалией страдают 5-15 детей из каждой тысячи новорожденных. Лечение состоит в отведении СМЖ за пределы ликворной системы в те полости тела, где она сможет абсорбироваться (поглощаться). Эффективная операция дает возможность ребенку нормально жить и развиваться, учиться в обычной школе, а взрослому — вернуться к полноценной, активной жизни. Тем не менее, пациенты и их близкие должны уметь распознавать признаки и симптомы послеоперационных осложнений для того, чтобы медицинская помощь могла быть оказала своевременно.
Классификация
По признаку открытости путей оттока ликвора гидроцефалия бывает:
- закрытой;
- сообщающейся;
- заместительной.
По особенностям деформации путей оттока:
- внутренней;
- наружной;
- смешанной.
По виду ликворного давления:
- гипотензивной;
- гипертензивной;
- нормотензивной.
По этиологии:
- врожденной;
- после воспалительного процесса;
- опухолевой;
- сосудистой;
- идиопатической.
Иные виды классификации:
- по течению;
- по фазе компенсации;
- по активности;
- по скорости развития.
Анатомия и физиология
Для того чтобы лучше знать и понимать болезнь, мы дадим Вам некоторые сведения об анатомии черепа, строении мозга, а также о процессе образования и поглощения спинномозговой жидкости (рис.1). Мозг занимает большую часть полости черепа. Он пронизан большим числом кровеносных сосудов и окружен ликвором, как буфером. Жидкость находится в 4-х полостях (желудочках), имеющихся внутри мозга. Желудочки имеют тонкие структуры, известные под названием ворсинчатых сплетений (сосудистые сплетения). Эти структуры производят значительное количество СМЖ — около 500 мл в сутки. Жидкость непрерывно циркулирует и содержит большое количество веществ, существенных для питания и обеспечения нормального функционирования нервной системы.
СМЖ создает также защитную подушку для мозга. СМЖ циркулирует в желудочковой системе и удаляется через 3 отверстия в 4-ом желудочке, а затем поступает в подпаутинное пространство, окружающее головной и спинной мозг.
СМЖ постоянно циркулирует в головном и спинном мозге, непрерывно находясь в процессе а) образования, б) циркуляции и с) поглощения. В здоровом организме эти процессы уравновешены. Гидроцефалия развивается, если СМЖ не выводится из желудочковой системы по ликворопроводящим путям. Реже причиной гидроцефалии является избыточное производство СМЖ как, например, при папилломе ворсинчатого сплетения.
Причина
Нейрохирурги насчитывают более 180 причин, способных вызвать развитие гидроцефалии. Она может быть врожденная (когда ребенок рождается с избыточным количеством ликвора в голове) или приобретенная вследствие других проблем:
– травматическая (развивается после перенесенной травмы, например, родовой, кровоизлияния в мозг), – воспалительная (развивается после нейроинфекций), – опухолевая (опухоль блокирует отток ликвора или стимулирует усиленную выработку), – сосудистая (вследствие сосудистых заболеваний головного мозга), – идиопатическая (когда причина не ясна).
В зоне риска – недоношенные дети и дети с иссеченной спинномозговой грыжей (т.к. спинной мозг связан с головным, часто гидроцефалия проявляется как сопутствующее заболевание). Чаще всего гидроцефалию обнаруживают до трехмесячного возраста, у мальчиков она развивается чаще, чем у девочек.
Диагностика
У новорожденных детей кости черепа еще не срослись и гидроцефалия определяется визуально. Голова увеличивается, кости черепа расходятся, родничок напряжен и выбухает; кожный покров тонкий и блестящий; вены в области волосяного покрова выглядят наполненными и припухшими. Также симптомами являются: рвота, апатия, возбудимость, смещение глаз вниз («симптом заходящего солнца») и т.д. Однако при не заросших черепных швах, признаки и симптомы увеличения внутричерепного давления кажутся неявными.
У детей более старшего возраста и взрослых кости черепной коробки сросшиеся и, при расширении желудочков, происходит сдавливание мозговой ткани. Появляются симптомы повышения внутричерепного давления: головные боли, тошнота, рвота, нарушение зрения, недостаточная координация, психопатологическое изменение личности, отсутствие концентрации и летаргия. Эти симптомы требуют дополнительного инструментального диагностирования.
Признаки проявления болезни
Симптоматика заболевания продиктована преимущественно сниженной перфузией мозговых тканей, перерастяжением групп нервных волокон (проводящих путей) на почве повышенного ВЧД.
- При остром патогенезе слабая микроциркуляция (гипоперфузия) ведет в основном только к функциональным расстройствам внутричерепного метаболизма. Это –
изменение энергообмена, сокращение уровня креатинфосфата и АТФ, увеличение концентрации молочной кислоты и неорганических солей фосфорных кислот. Острая клиника имеет обратимый характер. - Длительное существование гипоперфузии вызывает уже необратимые преобразования на структурном уровне. Это –
дефекты эндотелия сосудов и нарушение ГЭБ, аксональные повреждения (разрушение аксонов, вплоть до их полного исчезновения). Водянки продолжительного течения в конечном счете обуславливают атрофию головного мозга. - Морфология признаков при гидроцефалиях в сочетании с высоким внутричерепным давлением характеризуется, прежде всего, атрофией вещества ГМ и околожелудочковым отеком. Также присутствуют поражение мезенхимы сосудов, нарушение гомеостаза мозга, аксональные поражения, в нечастых случаях гибель нейронов. Данные признаки сочетаются с клиникой первичной патологии, спровоцировавшей гидроцефальный синдром.
Характерный для гидроцефалии симптоматический комплекс в раннем детском возрасте включает такие отличительные признаки, как:
- увеличенные размеры головы;
- учащенное срыгивание;
- беспокойное поведение ребенка;
- выбухание большого родничка;
- расхождение черепных швов;
- выраженность венозного рисунка на кожных покровах головы;
- задержка психомоторного развития, реже физического;
- запрокидывание головы назад;
- синдром «заходящего солнца» (Грефе);
- застойный диск зрительного нерва;
- параплегия нижних конечностей (при тяжелых, запущенных состояниях).
У взрослых и детей старшей группы клиническая картина зависит от того, какая по темпам течения форма у гидроцефалии. При острой форме заболевания, сочетающейся с высоким ВЧД, наблюдаются:
- распирающего и давящего характера головная боль, распространяющаяся на орбиты глаз (одной из особенностей является пик боли утром после ночного сна, а далее, в течение дня, выраженность болевого синдрома снижается);
- тошнота, которая обычно сопутствует утренней головной боли (нередко возникает рвота по утрам, после нее человек отмечает улучшение состояния);
- зрительные нарушения, как правило, беспокоят нечеткость зрения, затуманенность, двоение и ощущение жжения в глазах;
- усталость, сонливость, заторможенность;
- судорожные явления (по типу эпиприступа);
- при сдавливании ствола мозга вследствие дислокации мозговых структур – глазодвигательные расстройства, синдром вынужденного положения головы, помутнение сознания (вплоть до коматозного состояния), дыхательная недостаточность.
Водянка головного мозга в хронической стадии проявляется:
- признаками деменции (слабоумия), эмоциональной неустойчивости;
- апраксией ходьбы, чаще она проявляется шаткой и неуверенной походкой, несоразмерно большими шагами (находясь в положении лежа, зачастую пациенты не испытывают трудностей при имитировании ходьбы и кручения ногами «велосипеда»);
- снижением мышечной силы, иногда больные жалуются на боли в области шеи;
- сильным нарушением равновесия (на последних стадиях), которое выражается несостоятельностью человека в самостоятельном передвижении и сидении;
- частичным или полным выпадением чувствительности (не всегда!):
- недержанием мочи и/или кала (при массивном очаге).
Патология опасна своими жизнеугрожающими осложнениями! Ни в коем случае нельзя игнорировать срочное посещение врача при выявлении одного или нескольких симптомов из предоставленных списков. Своевременное обращение в больницу с целью диагностики и получения адекватной медицинской помощи увеличивает шансы на благополучный прогноз, вплоть до полного излечения.
В среднем из 10 больных, не получивших в нужное время лечение, 6-7 человек в скором времени умирает (это касается и детей). Те, кто не проходил терапию, но выжил, обречены на инвалидизацию с неврологическими нарушениями, умственными и физическими отклонениями с тенденцией прогрессирования.
Виды диагностических исследований
- Ультразвук — это простое, недорогое обследование, которое помогает оценить степень расширения желудочков мозга. В настоящее время является самым простым и безопасным методом диагностики гидроцефалии.
- Компьютерная томография (КТ) — Это техника вырисовывания тонким лучом контуров черепа, мозга, желудочков и под паутинного пространства. Проводится для определения размеров и формы желудочков и выявления аномалий типа опухолей, кист или другой патологии.
- Магнитный резонанс (ядерный магнитный резонанс ЯМР) — это не оперативный метод диагностирования, при котором используются радиосигналы и магнит. По данным МРТ определяются форма и выраженность гидроцефалии. Эти исследования незаменимы для уточнения причин возникновения водянки.
- Цистернография (рентгенография цистерн основания черепа) — это тест, требующий инъектирования радиоактивного вещества в СМЖ. Его применяют для уточнения типа гидроцефалии: сообщающаяся или обструктивная, а также для определения направления тока СМЖ.
- Пневмоэнцефалография сейчас применяется значительно реже, чем в прошлом. В некоторых случаях необходимо нагнетание воздуха с помощью иглы в спинной мозг.
- Ангиография (рентгенография кровеносных сосудов) — специальная техника введения контрастного вещества в артерии, пересекающие головной мозг. Через некоторое время выявляются аномалии на уровне кровеносных сосудов и наличие или отсутствие патологических нарушений.
- Нейропсихологическое обследование заключается в серии вопросов-ответов, позволяющих выявить наличие отклонений в работе головного мозга.
Эндоскопические операции
Эндоскопические техники оперативного вмешательства применяются в лечении окклюзионных гидроцефалий, среди них:
- вентрикулоцистерностомия;
- вентрикулярная кистоцистерностомия;
- вентрикулопластика Сильвиева водопровода;
- септостомия;
- этиотропная эндоскопия (избавление от причинного фактора – удаление опухоли, кисты, гематомы или др.).
В 90% случаев используют метод эндоскопической вентрикулоцистерностомии. Смысл такой операции – перфорация дна III желудочка головного мозга под контролем эндоскопа через миниатюрное трепанационное окно. Созданный в ходе эндоскопической процедуры анастомоз позволяет восстановить естественный путь оттока ликвора между III желудочком и базальными цистернами ГМ.
Эндоскопия любого вида – более щадящая тактика нейрохирургии, она не требует вживления в организм чужеродных тел и менее редко вызывает послеоперационные последствия. Несмотря на перспективные характеристики эндоскопических методов, в ряде случаев без шунтирования или без применения открытой микрохирургии не обойтись.
Современные технологии нейрохирургии оточены до совершенства в Чехии, хирургия мозга в этой стране является ведущей областью медицины. Нейрохирургическая помощь в клиниках Чешской Республики оказывается ничуть не хуже, чем в Германии и Израиле, зато гораздо ниже цены (примерно в 2 раза). Людей с таким диагнозом здесь оперируют на самом образцовом уровне, а по окончании полного курса реабилитации выписывают с отличными и хорошими результатами.
Лечение
В настоящее время окклюзионную (обструктивную) гидроцефалию лечат хирургическим путем. Хирургическое вмешательство заключается в отведении избыточной спинномозговой жидкости за пределы ликворной системы: в брюшную (абдоминальную) полость или в предсердие. Иногда СМЖ может отводиться в плевральную полость. В этих полостях ликвор всасывается и выводится вместе с продуктами распада организма.
Для отведения СМЖ хирург имплантирует дренажную систему (шунт). Материалом системы являются силикон и полипропилен. Оба эти материала хорошо переносятся организмом. Все элементы системы имплантируются под кожу, наружных участков нет.
Компоненты шунтирующей системы
Система состоит из двух катетеров и одного клапана одностороннего действия. Вентрикулярный катетер находится в желудочке мозга, а периферический (перитонеальный или кардиальный) помещен в брюшную полость или в правое предсердие соответственно. Оба катетера соединены с клапаном, регулирующим однонаправленный отток спинномозговой жидкости. Клапаны рассчитаны на работу в различных диапазонах давления (высокое, среднее, низкое и очень низкое). Нейрохирург, определив внутричерепное давление пациента, подбирает подходящий клапан, в зависимости от выраженности болезни, возраста пациента и клинических нюансов.
Почти все модели клапанов имеют резервуар, с помощью которого Ваш врач может «прокачивать» систему, определяя правильность ее работы. Из резервуара путем введения через кожу тонкой иглы можно брать пробы ликвора на лабораторные исследования или вводить лекарственные препараты. Пациентам и их близким не рекомендуется проверять отводящую систему путем «прокачивания» резервуара. Подобное действие может быть опасным, если только врач не дал Вам точных инструкций по этому поводу. У пациентов, страдающих не сообщающейся (обструктивной) гидроцефалией отведение ликвора должно происходить из желудочка мозга с помощью вентрикулярного катетера. Пациентам же с сообщающейся гидроцефалией имплантируют систему дренирования СМЖ из люмбального пространства позвоночника в брюшную полость — люмбоперитонеальную систему.
Варенька: и не таких вытягивали!
Когда в год Лена привезла свою Варю домой, в Сортавалу, и ее положили в их местную больницу, врачи в недоумении разводили руками:
– Будем лежать и наблюдаться. – То есть умирать? – Ну, да.
И вот тут Лена поняла, что не может так просто ждать, когда дочь умрет. Она вызвала платную скорую и помчалась в Петербург. А оттуда на поезде, с Варей на руках – в Москву. «В дороге она у вас умрет!» – напутствовали ее в больнице. Но она нашла платного врача, который ее будет сопровождать, и поехала.
Она уже знала, что в Москве есть Дмитрий Зиненко, для которого гидроцефалия – не приговор и не страшилка.
– И не таких вытягивали, – сказал Дмитрий Юрьевич, глядя на Варю, у которой из шести килограммов общего веса четыре килограмма весила голова.
В Москве Варе поставили новый шунт, вывели его в предсердие, а позже – в брюшную полость. И девочка ожила. Лена с Варей прошли два курса в петербургском реабилитационном . И уже после первого курса Варя начала поднимать голову. А спустя год начала переворачиваться, ползать, садиться и ходить вдоль опоры.
– Главное – мы сейчас дома и все вместе! – не нарадуется Лена.
Трехлетний Степа, развитый по возрасту, лихо залез на стул и дотянулся до красок, которые спрятала мама. И вот они уже на пару с Варей малюют что-то на полу. Они здорово сработались – двойняшки.
– Родственники в Варе души не чают, – говорит Лена. – И главное – с тех пор, как Варя вернулась домой, у нас никогда не бывает ссор, никто ни на кого не кричит. Разве что дети подерутся друг с другом иногда. Ну, дети же!
Хирургическая операция и госпитализация
Имплантация шунтирующей системы проводится нейрохирургом в стерильных условиях операционной. При подготовке к операции волосы сбривают для достижения максимальных условий чистоты. Операция проходит под общим наркозом, как правило, не очень длительное время. Нейрохирург высверливает небольшое отверстие в кости черепа, затем производит небольшой разрез в твердой оболочке головного мозга, защищающей мозг, и вводит вентрикулярный катетер в боковой желудочек. Для имплантации остальной части шунтирующей системы делаются еще один разрез и подкожно проводится тоннель для имплантации перитонеального или кардиального катетера. Конец катетера аккуратно вводят либо в брюшную полость, либо в шейную вену, идущую к желудочку сердца. Катетеры соединяются с клапаном с помощью коннекторов на самом клапане. Все детали шунта, таким образом, соединены в единую дренирующую систему. По окончании операции небольшие стерильные повязки накладываются на каждый надрез.
Сразу после операции больного отвозят в послеоперационное отделение. Пациент здесь находится от 1 часа до 1 суток под внимательным наблюдением, затем его переводят в палату. Большинство пациентов выписывают через 7-10 суток после клинической реабилитации.
Аленка: ей все можно!
10 лет Светлана без устали объясняет неврологам на приеме, что «желудочек» – это не «маленький желудок», это – часть головного мозга. И шунт стоит у дочки не в животе, а в голове.
Но она не устала, она готова и дальше этим заниматься. Просвещать. Вдохновлять. Информировать.
«Зачем я пишу о дочке, ее успехах? Иногда так хочется забраться поглубже в берлогу и никого туда не пускать. Но я вижу, как эти посты вдохновляют тех родителей, которые только столкнулись с этим диагнозом. Они видят Аленку на лошади, на конкурсе чтецов, на встрече с продюсером Максимом Фадеевым – и верят в лучшее.
Однажды мы с Аленкой и моей старшей дочерью Настей отправились в конный поход, я нервничала из-за старшей и все время кричала ей: «Настя, держись! Настя, держись!»
Наконец инструктор не выдержал и говорит: «Да она и так лучше всех держится» и указывает на Аленку. Я смеюсь: «Да я знаю, я старшей кричу».
Аленка и в седле уверенно держится, и на сцене. В школе ни один спектакль без нее не обходится. Она, даже когда ходить еще не могла, играла… Колобка!
Чего ей никак пока не удается – всерьез заняться музыкой (часто лежим в больницах, сложно организовать постоянный график занятий) и танцами (танцы для колясочников ей не подходят – она уже вышла из коляски, а обычные пока не получаются)».
Но, глядя на Аленку и ее маму, можно уверенно сказать: «Это ПОКА не получаются!» Когда-то врачи, глядя на шунтозависимую Алену, говорили только: «Сидите около реанимации и не рыпайтесь!»
И только Дмитрий Юрьевич Зиненко (ныне – заведующий нейрохирургическим отделением НИКИ педиатрии им.Ю.Е.Вельтищева) сказал: «Вам можно все! Хоть в космос летите, хоть дайвингом занимайтесь».
«Неслучайно нас всех, его пациентов, в шутку называют «зиненкозависимыми». Он подарил нам шанс на обычную жизнь.
Аленка, например, не разрешает мне наклеивать на машину инвалидный знак. А есть такие дети с гидроцефалией, которым и вовсе не оформляли инвалидность. Они просто живут, как все. Конечно, невозможно совсем расслабиться и не думать про шунт. В любом состоянии хоть краешком сознания контролирую ее.
Не упала? Не ушиблась? Не тошнит ее? Если тошнит – сразу на скорую и в больницу. Если ребенка с шунтом вырвало – первым делом исключаем проблемы с шунтом. Все остальное – отравление, инфекция – потом. И все же я стараюсь не зацикливаться на мыслях о шунте, а просто жить. Вот, думаю, Аленке все-таки надо попробовать заняться музыкой: у нее идеальный слух».
Участие в уходе
Дети с имплантированными шунтами должны наблюдаться у нейрохирурга на протяжении всей жизни. Большинство пациентов, страдающих гидроцефалией, после имплантации им шунтирующей системы, могут вести нормальный образ жизни, но необходим постоянный контроль со стороны близких в сотрудничестве с нейрохирургом.
Нейрохирург наблюдает каждого пациента для предупреждения сбоя в работе дренажа. Первое время после имплантации или повторной операции — регулярно, с постепенным переходом к обследованиям с частотой 1 раз в год.
Близким рекомендуется уметь распознавать ранние признаки осложнений. Очень важна быстрая и точная оценка проблем со здоровьем. Симптомы гриппа могут маскировать симптомы закупорки шунта. Быстрое выявление их позволит спланировать повторную операцию и избежать чрезвычайной ситуации.
Пациенты и их близкие должны обращать должное внимание на признаки и симптомы осложнений. Основными причинами являются: закупорка, инфекция и чрезмерное дренирование.
Варенька: страдания были связаны с шунтом
– Я еще в детстве знала, что у меня будет сын Степка и дочь Варенька. Но как-то не складывалось, – рассказывает Елена Кирина из города Сортавала (Карелия). Семь лет у нас с мужем не было детей. Обследовались, лечились. Наконец мне сказали, что я беременна и у меня двойня, от радости упала на пол и заревела. А потом в 14 недель на УЗИ стало понятно, что у Варюши синдром Денди-Уокера, мозжечок не развивается и она, скорее всего, не выживет, а если и выживет, то станет инвалидом. Нам предлагали сделать аборт, но при аборте мог пострадать Степка. Да и вообще я всегда была против абортов. Мы решили рожать. Весь оставшийся срок беременности я проплакала. На 33-й неделе начались роды. Сделали кесарево сечение. Варю я совсем не увидела – она не дышала, ее сразу унесли.
На 9-й день у Вари стала развиваться гидроцефалия. В три месяца ей поставили первый шунт. Но девочка страдала. В общей сложности она перенесла восемь операций. У нее засорялся шунт, был заражен ликвор. По сути она была обречена. Целый год она провела в больницах Петрозаводска и Петербурга. А Лена, которая не могла оставить надолго Степана (у него тоже были проблемы со здоровьем), провела за этот год времени в дороге больше, чем с дочерью.
– Дома у меня был маленький ребенок, а я бесконечно плакала и хотела задушить сама себя. Потому что другой мой ребенок одиноко умирал в больнице.
Проблема была в том, что Варю держали в инфекционном отделении, полагая, что ее симптомы – следствие вируса. А ее страдания были связаны именно с шунтом.
Закупорка
Основным типом осложнения является закупорка системы. Закупорка может иметь место на любом уровне дренажа. Отверстия на вентрикулярном катетере могут забиться мозговой тканью или тканью ворсистого сплетения. Он может быть перекрыт также за счет избыточного сокращения желудочковой полости вследствие слишком интенсивного отвода жидкости из желудочковой полости (синдром суженного желудочка). К перитонеальному катетеру могут прилипнуть кишечные петли или некротические ткани. Шунты, введенные в желудочек сердца, могут закупориваться сгустками крови, фрагментами мозгового вещества или опухолевыми клетками.
Шунтирующая система также может быть разобщена при отсоединении различных элементов шунта или за счет изменения положения катетера, вызванного ростом ребенка. Необходимо проведение рентгенографии для проверки целостности шунта.
Частичная закупорка деталей системы провоцирует появление симптомов повышенного внутричерепного давления. Могут появиться эпизодические головные боли, тошнота, апатия и снижение чувственных функций. Снижение работоспособности в школе или на работе наиболее частые явления в этих условиях.
В случае полной закупорки симптомы развиваются быстрее (головные боли, тошнота, рвота, нарушение зрения, потеря координации и расстройство сознания). Пациент впадает в ступор или кому. В подобных случаях необходима срочная госпитализация для наблюдения и проведения соответствующего лечения.
Хирург проводит серию тестов с целью локализации и определения степени закупорки дренажа. Иногда следует удалить и заменить частично или полностью всю систему.
Дмитрий Зиненко: гидроцефалия – загадочное заболевание
– Гидроцефалия – самое загадочное заболевание центральной нервной системы, у которого до сих пор нет общепринятого определения. Но, несмотря на это, мы научились излечивать гидроцефалию, – говорит заведующий отделением нейрохирургии НИКИ педиатрии Дмитрий Юрьевич Зиненко. – Если лечить ее вовремя и адекватно, то она проходит без последствий для ребенка.
– И спортом можно заниматься?
– Дети живут полноценной жизнью. Правда, нужно сказать, что причиной гидроцефалии могут быть: гипоксия, кровоизлияния, травма, инфекция и другие заболевания, которые сопровождаются поражением головного мозга, что и определяет тяжесть состояния ребенка, а не гидроцефалия как таковая. Но именно гидроцефалию своевременно распознать и адекватно вылечить можно.
– А могут специалисты ее «проглядеть»?
– Водянка головного мозга диагностируется чаще всего у детей до года. Она всегда протекает с повышенным внутричерепным давлением, которое имеет яркие проявления: быстрый рост окружности головы, вздутые вены на голове, набухающий родничок. Яркая картина, невозможно не заметить. Если говорить о диагностике, то чаще мы имеем дело с гипердиагностикой.
В 90% случаев диагноз «гидроцефалия» ставят там, где его нет.
А вот когда больному поставили шунт, тогда появляются другие проблемы. Чаще приходится сталкиваться, наоборот, с недооценкой тяжести состояния ребенка. Давление становится не высоким, а низким. А это еще больше тормозит развитие ребенка.
Иногда приходится сталкиваться с таким мнением: поставили шунт, желудочки уменьшились – и хорошо. А если ребенок по-прежнему не может находиться вертикально – это воспринимается как естественное проявление самой болезни.
А на самом деле, если желудочки уменьшились – это катастрофа. Голова перестала расти – это катастрофа. Ребенок не может долго находиться вертикально – это катастрофа. Это все признаки того, что шунт слишком хорошо работает. Надо поменять шунт и уменьшить отток жидкости. Из экономии, в основном, ставят шунты, которые не отвечают всем потребностям организма.
– Некачественные?
– Как вам сказать… Можно купить «Жигули». Хорошая машина. Но она обладает своим пределом возможностей. А можно купить «Мерседес». У него и возможностей побольше, и безопасность выше. Но и цена другая. Вот так и с шунтами. К сожалению, шунты на фиксированное давление – это такие «Жигули». Они доступны, но приводят к огромному количеству осложнений. Это как кран, который всегда открыт на один и тот же поток жидкости, который может не подходить конкретному ребенку.
Нужно сразу ставить программируемый шунт. Тогда мы можем регулировать отток жидкости для каждого ребенка индивидуально без повторных операций. Они дорогие, но в конечном счете они позволяют избежать многих осложнений и в целом для системы здравоохранения они обходились бы дешевле. Ну и самое главное – безопаснее для ребенка.
– Вы оперировали маленького Матвея вместе с известным индийским хирургом Сандипом Вайшья, когда уменьшали у него объем головы, последствие гидроцефалии. Для вас это был уникальный опыт?
– Конечно, любой обмен опытом бесценен. Мы тоже делаем такие операции, но было полезно поработать вместе с прекрасным хирургом, увидеть его технику, обсудить подходы. Эта операция сегодня эксклюзивна только потому, что сейчас такие большие головы стали редкостью. Гидроцефалия удачно лечится на ранних этапах. Совсем не нужно ждать, пока голова станет такой большой.
Голова на день рождения: хирурги-волонтеры лечат сирот от гидроцефалии
Инфекция
Инфекция является вторым типом осложнения. Она представляет значительный риск для любого хирургического вмешательства, чаще всего при имплантации чужеродного тела.
Проявляется она в виде покраснения или нагноения по краям шва или вдоль пути прохождения дренажной системы под кожей. Хирург фиксирует свое внимание на этих признаках. Если не провести лечение, может произойти эрозия или раскрытие раны, в более серьезных случаях инфекция проявляется в ознобе и лихорадке. Как правило, необходимо извлечение дренажа. Иногда можно провести терапию антибиотиками без извлечения системы.
Поскольку шунт является инородным телом, у пациента может возникнуть аллергия или воспалительная реакция. Воспаление на одном из участков дренажа должно быть немедленно показано нейрохирургу.
Избыточный дренаж
Избыточное отведение спинномозговой жидкости происходит при неправильном подборе клапана по параметру давления. Слишком низкое давление открытия клапана может привести к чрезмерному дренированию, при этом желудочек мозга сжимается и происходит деформация мозговой ткани. У пациента возникают головные боли, наиболее чувствительные, когда он стоит.
Кроме того, появляется тошнота, рвота, сонливость и расстройства нервной системы, в частности, двоение в глазах. У детей школьного возраста отмечается снижение умственных способностей.
Особенности реабилитации
Когда процедура завершится, а шунт будет в голове, пациент начнет ощущать недомогание. Зачастую оно сопровождается легкой тошнотой, головокружением, головной болью разной интенсивности, легким онемением конечностей. Все эти ощущения могут быть выражены с разной силой. Это является нормой.
На второй день после проведения операции врач должен оценить успешность шунтирования. Для этого пациенту нужно пройти МРТ, что поможет проверить состояние головного мозга и исключить вероятность развития осложнений после проведенного вмешательства. Если все в порядке, то повторные обследования проводятся еще через неделю и сразу при выписке из больницы. Общее время восстановления именно в стационаре составляет 14 дней.
Выглядеть человек после установки шунта будет нормально, т.к. все его компоненты практически незаметны.
Процесс реабилитации
После выписки из больницы человек должен вести особый образ жизни, который позволит максимально правильно восстановить свой организм после перенесенной операции. Установка шунта сама по себе требует особого внимания, т.к. многие факторы могут оказать негативное влияние на будущее состояние человека и вызвать осложнения.
От выздоравливающего требуется выполнение простых правил:
- Полный отказ от алкоголя и сигарет до полного восстановления организма.
- Исключение любой физической нагрузки. Полный запрет на подъем тяжестей и всяческие домашние или дачные работы.
- Отказ от вождения автомобиля и всех видов работ, для которых необходима концентрация. Есть риск неадекватной реакции на стрессовые ситуации, что приведет также к осложнениям.
- Домашний режим на 30 дней. При этом запрещается посещать бассейны и водоемы, находиться на улице дольше необходимого времени, особенно, если погодные условия кажутся неблагоприятными.
- Отсутствие прикосновений к голове в области послеоперационного отверстия. Любой контакт с этой областью может вызвать травму и быстрое проникновение инфекции. Также запрещается самостоятельно пытаться убирать шунт.
- Прием всех выписанных лекарств согласно с указаниями врача. Пациенту назначают противосудорожные препараты. При этом важно следить за своим самочувствием, т.к. они имеют ряд побочных эффектов.
На протяжении всего реабилитационного периода очень важно четко следовать инструкциям своего лечащего врача. Только так получится избежать проблем в будущем и максимально быстро вернуться к привычной жизни. Пациент еще очень долго проживет полноценную жизнь практически без ограничений. Продолжительность жизни тех, кого пришлось прошунтировать, практически не отличается от среднестатистических показателей здоровых людей.
Очень важно работать над собой, настраивая себя психологически на быстрое выздоровление. Реабилитация без этого будет менее успешна.
Необходимость замены шунта
Необходимость присутствия шунта остается навсегда. Поэтому шунтозависимый должен максимально серьезно относиться к своей проблеме. Это не так удобно, как хотелось бы большинству больных, но гораздо важнее результат с возможностью спокойно жить.
Время от времени шунт требуется менять. Постепенно он теряет свою эффективность. Причиной тому становится закупорка, износ, различные случайные повреждения. Сказать, сколько времени прослужит шунт, невозможно. Рассчитаны они на срок службы до 10 лет. Однако часто их приходится менять намного раньше, вне зависимости от качества. Особенно, если речь идет о детях. Вместе с их постепенным ростом потребуется удлинение и шунта. Замена производится очень быстро и безболезненно.
При первой необходимости проверки оборудования или его замены следует незамедлительно обращаться к лечащему врачу, т.к. вмешательство специалистов будет необходимостью. Снимать его может только опытный сотрудник медицинского учреждения.
Считается ли больной инвалидом
Больные, перенесшие шунтирование мозга, могут рассчитывать на присвоение степени инвалидности. Это определяется комиссией, которая принимает решение на основе проведенных исследований. Как ребенок, так и взрослый человек могут быть признаны инвалидами, если у них будут определены нарушения основных категорий жизнедеятельности, к которым относятся следующие способности:
- самообслуживание;
- ориентация в пространстве;
- передвижение;
- обучение;
- самоконтроль;
- общение;
- трудовая деятельность.
Инвалидность потребуется постоянно подтверждать на обследованиях.
Дополнительная информация о шунтирующих системах для лечения гидроцефалии
От качества шунтирующей системы во многом зависит результат операции. Во многих стационарах нейрохирурги последние годы используют шунтирующие системы производства крупнейшей американской фирмы Медтроник. Инженерами фирмы совместно с ведущими нейрохирургами США разработан целый ряд клапанов различных моделей и размеров (включая клапаны для новорожденных детей).
Одним из последних достижений в производстве ликвородренирующих устройств стал клапан Дельта. Это уникальный клапан, не имеет аналогов других производителей. Он создавался под задачу избежать такого частого осложнения, как чрезмерное дренирование СМЖ. Если все остальные клапаны пропускают столько жидкости, насколько они рассчитаны по давлению, то клапан Дельта пропускает столько жидкости, сколько нужно, чтобы ее осталось в желудочке для поддержания внутричерепного давления в пределах физиологической нормы. При имплантации клапана Дельта у больного поддерживается нормальное давление, независимо от скорости вырабатывания ликвора и, главное, независимо от положения тела пациента (лежа/стоя).
Технологические особенности материалов, из которых изготовлены клапаны системы, не допускают деформации и слипания при прокачивании, купол резервуара клапана рассчитан на многократные прокалывания тонкой иглой (отверстия сомозатягиваются). Катетеры изготовлены из высококачественного силикона без примеси латекса, поэтому не слипаются и не образуют петель, что значительно снижает риск закупорки системы.
Клапаны оснащены коннекторами для соединения с катетерами, их конструкция облегчает соединение и уменьшает возможность отсоединения и разобщения системы.
По протяженности катетеров нанесена рентгеноконтрастная метка, это позволяет увидеть шунт при рентгене. Таким же веществом на клапане нанесен точечный код, обозначающий давление клапана. В шунтирующей системе нет металлических деталей. Это очень важно при проведении КТ и ЯМР — исследованиях, т.к. металл будет давать артефакты, а магнит при ЯМР может сместить местоположение системы (если бы в ней были металлические детали).
Все системы стерильны и доставляются в двойной стерильной упаковке. Для снижения риска инфицирования фирмой Медтроник разработан уникальный гидрогель БиоГлайд. Он наносится на внутреннюю и внешнюю поверхности катетеров, а также на внешнюю поверхность клапана и не отслаивается. Нейрохирург перед имплантацией может обработать детали системы антибиотиками, а гидрогель удержит их в течение 3-х суток для проведения послеоперационной антибактериальной терапии внутри организма пациента. Таким образом, риск инфицирования сводится к минимуму.
Матвей: ждет маму
У Матвея от гидроцефалии выросла такая большая голова, что до трех лет он не мог даже ее поднять. Нет, не по недосмотру. Да, юная 17-летняя мама отказалась от него сразу после родов. Но заботливые руки Елены Евгеньевны Шатской, главврача того учреждения для детей-сирот в Рязанской области, которые приняли Матвея, и ее коллеги сделали для него все возможное. И даже невозможное. Шунтирование, проверка шунтов, замена. Все осложнял врожденный порок мозга.
Когда возможности региональных нейрохирургов были исчерпаны, Елена Евгеньевна добралась до федеральных. И вот уникальную операцию по уменьшению головы (краниопластику) трехлетнему Матвею в два этапа сделали лучшие российские нейрохирурги совместно с приглашенным индийским хирургом Сандипом Вайша.
После первой же операции малыш перевернулся на живот, а после второй – начал вставать на четвереньки и поднимать голову.
Сегодня 4-летний Матвей может сам присаживаться и находиться в сидячем положении довольно долго. Это значит, что теперь он и ест, и гуляет сидя. У него расширился рацион питания (оказалось, он обожает бананы и клубничные творожки), увеличился обзор, появились новые эмоции.
– Даже такое тяжелое сочетание диагнозов не повод, чтобы «ставить крест» на ребенке. Мы не можем гарантировать ему обычную жизнь обычного малыша, но мы можем улучшить качество его жизни, дать ему шанс, использовать тот реабилитационный потенциал, который у него есть. Не знаю, будет ли он учиться в обычной школе, но есть надежда, что он будет ходить!
Самое главное наше переживание в том, что через год мы обязаны передать нашего улыбчивого мальчика в интернат для детей с тяжелой умственной отсталостью. А вот если бы у него нашлась семья! Мы бы с огромной радостью предоставили им все наши реабилитационные возможности, – мечтает Елена Евгеньевна. – Уверена, он составит чье-то родительское счастье!
Эмоциональная поддержка
Физическая сторона гидроцефалии является лишь частью проблемы этого заболевания. Пациенту и его близким необходимо принимать во внимание и эмоциональные его факторы.
Хотя хирургическое вмешательство должно в какой-то степени разрешить проблему гидроцефалии, вы можете испытывать страх, подавленность, раздражительность или сомнение. Если пациентом является ребенок, следует принимать в расчет, что ему свойственны те же чувства, что и взрослому. Если ребенок чувствует себя не в форме, испытывает дискомфорт из-за того, что ему необходимо часто посещать врача или проходить повторные тесты, лучше всего успокоить его простыми объяснениями. Если он знает, что ему предстоит, он охотней пойдет на сотрудничество с Вами. Дети, как и взрослые, как правило, не любят неприятных сюрпризов. Спокойная атмосфера среди любящих близких является наилучшей средой для детей. Желательно объяснить явление гидроцефалии в понятных ребенку словах.
Очень важно знать о том, что чувствует ребенок и уметь объяснить ему то, что он испытывает. Иголки причиняют боль. Естественным является плач и желание избавиться от них. Помещение в больницу является новым испытанием для Вашего ребенка. Вы должны говорить ему правду для того, чтобы вызвать и закрепить его доверие. Искренность — наилучшее средство сохранения доверия Вашего ребенка.
Дети старше десяти лет, как правило, способны воспринимать более сложные понятия. Они могут связывать признаки и симптомы со своим заболеванием. Ограничения, связанные с болезнью, переносятся ими легче. Расскажите о своих чувствах Вашему врачу и предоставьте ему право руководить Вами. Некоторые люди делятся своими чувствами с близкими друзьями, другим необходима профессиональная помощь. Профессионалы в области здоровья, лечащие Вас или Вашего ребенка, заинтересованы в Вашем благополучии, их цель – сделать все лучшее для Вас и Ваших близких.
Пациенты и родители пациента должны довольно часто общаться со своим врачом. Очень важно активно участвовать в этом общении, чтобы врач мог лучше понимать Ваши нужды и нужды Ваших близких.
Аленка. Сбросить стигмы
Светлана Лисунова, активист МБОО помощи детям с нейрохирургическими заболеваниями «Ты ему нужен», мама Аленки с постгемморагической окклюзионной гидроцефалией, рассказывает:
«Я стояла под дверью реанимации и только слышала: «Это уже труп. Что ты в нее вцепилась», «Представь, что это аборт», «Лучше сейчас один раз поплачь, чем потом всю жизнь плакать»
Тяжелые роды. Кровоизлияние в мозг. Про дочь сразу сказали: «не выживет». И, вероятно, поэтому не особенно ею занимались. В реанимации она лежала 12 часов без искусственной вентиляции легких. Просто лежала и задыхалась.
«Больничный? Вот умрет – приходи за больничным». Крестить не разрешили: «Нечего тут грязными рясами трясти». Сцеженное молоко не брали: «Нам тут твоя козья моча не нужна».
В три месяца Аленку, не дождавшись ее смерти, все-таки выписали домой. Уже через неделю Светлана поняла: нарастает гидроцефалия. Аленка резко плакала, сильно срыгивала, глаза ее буквально лезли на лоб – наверное, ее мучили сильные головные боли. Скапливающийся ликвор стал давить на мозг.
Светлана – врач по образованию. Распознать гидроцефалию она могла. А что дальше? Конечно, она, ортопед по специальности, проходила курс нейрохирургии в очень усеченном виде. Но что именно? Достала учебники. «Состояние, не совместимое с жизнью… умирают в первые дни жизни… родители, страдающие наркотической и алкогольной зависимостью…»
Следующие десять лет жизни Светлана посвятила тому, чтобы опровергнуть каждую из этих строчек того заскорузлого учебника. Сбросить стигмы.
Сегодня она – активист общественной организации «Ты ему нужен». А ее Аленка – 10-летняя красавица и отличница. Ее друзья, подопечные, коллеги – сотни родителей детей с гидроцефалией.
Среди них нет ни одного человека с зависимостями. Подавляющее большинство случаев гидроцефалии, с которыми она сталкивается, корнями уходят в родовые травмы, кровоизлияния в мозг. Небольшой процент детей получили врожденную гидроцефалию (обычно она тоже связана с внутриутробными травмами – авариями и проч.). И небольшой процент гидроцефалий связан с перенесенными матерью во время беременности инфекциями.